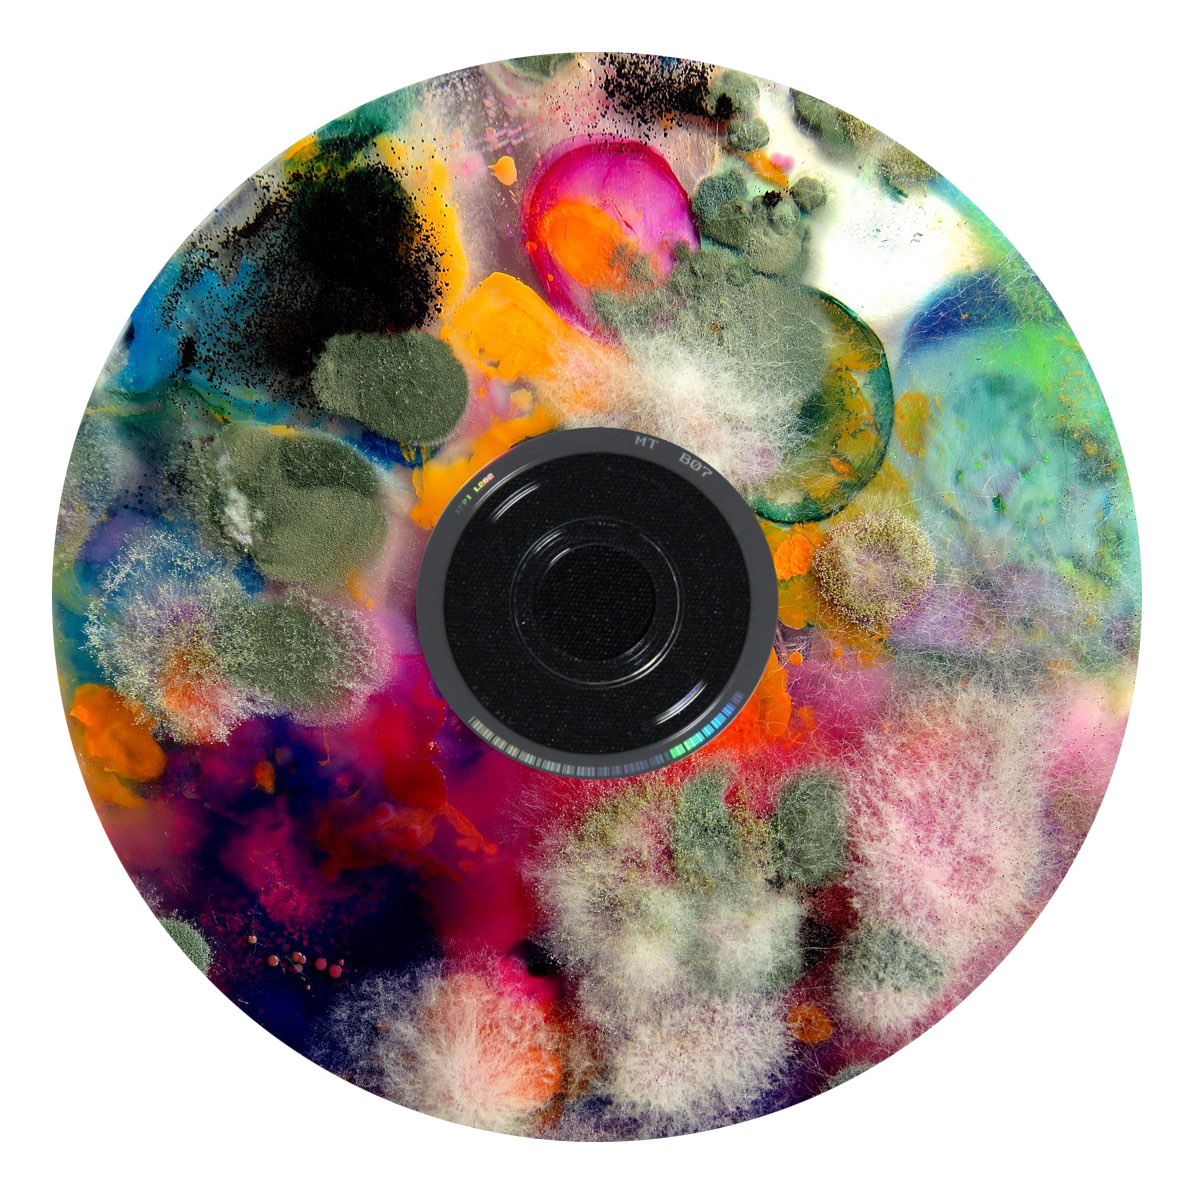

ВСЕЛЕННАЯ НАМНОГО БОЛЬШЕ, ЧЕМ ВЫ СЕБЕ ПРЕДСТАВЛЯЕТЕ


ЕСЛИ ВЫ ВДРУГ НЕ ЗНАЛИ, ЧТО ИЗ СЕБЯ ПРЕДСТАВЛЯЕТ ВСЕЛЕННАЯ, ОТВЕЧАЕМ — ЭТО БЕЙГЛ • ВСЕ ВОКРУГ НЕРАЗРЫВНО СВЯЗАНО ДРУГ С ДРУГОМ В БЕСКОНЕЧНОМ КРУГОВОРОТЕ. ВЫ И ВСЁ, ЧТО ВЫ КОГДА-ЛИБО ЗНАЛИ, СОСТОИТ ИЗ БЕЙГЛА. И БЕЙГЛ СОСТОИТ ИЗ ВАС. БЕЙГЛ — ЭТО ПРОШЛОЕ, НАСТОЯЩЕЕ И БУДУЩЕЕ. А ЕСЛИ ВАМ КАЖЕТСЯ, ЧТО ЭТО НЕ ТАК, ТО ВЫ ПРОСТО НЕ ПРЕДСТАВЛЯЕТЕ, НАСКОЛЬКО ВСЕЛЕННАЯ БОЛЬШЕ ГРАНЕЙ НАШЕГО ПОНИМАНИЯ.


Вы правда считаете, что Бейгл — это просто?

БЕЙГЛ РЕАЛЬНЫЙ
Просто бейгл — выпечка
из дрожжевого теста. Брат бублика.
Просто бейгл — выпечка
из дрожжевого теста. Брат бублика.
БЕЙГЛ МЕТАФОРИЧЕСКИЙ
Всем знакомые
и известные айтемы, напоминающие бейгл формой, цветом, ассоциацией.
Всем знакомые
и известные айтемы, напоминающие бейгл формой, цветом, ассоциацией.

БЕЙГЛ ВСЕМОГУЩИЙ
«Как-то раз мне стало скучно, и я решила сделать бейгл со всем. Буквально всем».
— Джобу Тупаки
«Как-то раз мне стало скучно, и я решила сделать бейгл со всем. Буквально всем».
— Джобу Тупаки


























БЕЙГЛ РЕАЛЬНЫЙ


















БЕЙГЛ МЕТАФОРИЧЕСКИЙ




















































БЕЙГЛ ВСЕМОГУЩИЙ











































ВСЕ ЕЩЕ СОМНЕВАЕТЕСЬ?


ПОДРОБНЕЕ С ВИЗУАЛЬНЫМ ИССЛЕДОВАНИЕМ МОЖНО ПОЗНАКОМИТЬСЯ ТУТ
НАШ САЙТ НЕ ИСПОЛЬЗУЕТ COOKIES. МЫ ПРЕДПОЧИТАЕМ BAGELS: ОНИ ЗАПОМИНАЮТ ВАШИ ДЕЙСТВИЯ И ПРЕДПОЧТЕНИЯ ДЛЯ БОЛЕЕ УДОБНОЙ РАБОТЫ В ПРОСТРАНСТВЕ.
OK
